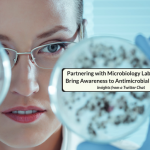

In this article an infectious diseases pharmacists discusses the MAD-ID conference, which is known as The Antimicrobial Stewardship Meeting, Making A Difference In Infectious Diseases (MAD-ID). Authored by: Timothy P. Gauthier, Pharm.D., BCPS, BCIDP Article Posted 16 May 2023 People practicing in the area of infectious diseases and antimicrobial … [Read more...]
5 Things To Know About Antimicrobial Stewardship Regulatory Standards
In this article an infectious diseases pharmacist with experience managing antimicrobial stewardship programs discusses antimicrobial stewardship regulatory standards Authored by: Timothy P. Gauthier, Pharm.D., BCPS, BCIDP Article Posted 14 April 2023 In 2014 CDC released the Core Elements of Hospital Antibiotic Stewardship Programs (Core Elements) … [Read more...]
Partnering With Microbiology Laboratory To Bring Awareness To Antimicrobial Resistance
In this article three infectious diseases pharmacists discuss the cross-roads of antimicrobial resistance and microbiology laboratory, reflecting on a recent Twitter chat on the topic. Authored by: Patrick McDaneld, Pharm.D., BCIDP, Brian Raux, Pharm.D., BCIDP, and Katherine Perez, Pharm.D., BCPS-AQ ID Article Posted 25 March 2023 Active … [Read more...]
Top 10 Journal Articles To Read During Your Infectious Diseases Pharmacy Rotation
In this post a top 10 list of journal articles to read during an infectious diseases pharmacy rotation is provided. Authored by: Timothy P. Gauthier, Pharm.D., BCPS, BCIDP Article Posted 12 March 2023 As a pharmacist serving as a preceptor to students and residents in the area of infectious diseases since 2010, I have always been on the hunt for … [Read more...]
Best Infectious Diseases Articles From 2022 – A Year End Review Of Non-COVID Literature
In this article a selection of the top infectious diseases articles from 2022 are identified. Article Selection by: Bassam Ghanem, Pharm.D., MS, BCPS Article Construction by: Timothy P. Gauthier, Pharm.D., BCPS, BCIDP Article Posted 3 January 2023 Coming out of 2020 and 2021, to nobody's surprise 2022 was yet again a very busy year for folks … [Read more...]